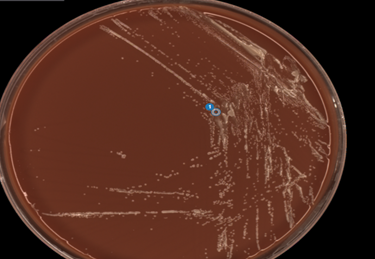

Case history
A 47 year old male with an extensive ocular history including laser assisted in situ keratomileusis (LASIK), multiple ocular traumas with repair, and myopic degeneration with neovascularization for which he was prescribed hard and soft contact lenses presented for bilateral eye redness, watering, and stinging pain. Recently, he had forgotten his soft contacts and wore his hard lenses to his job in construction which he reported doing once every 1-2 months. Ocular exam revealed only his usual chronic changes. His symptoms improved with moxifloxacin eyedrops, but never fully resolved. A month later he returned with what was initially assessed as diffuse corneal edema and conjunctival injection in his left eye, but no ring infiltrate or epithelial defect. Two days later, a large epithelial defect with surrounding ring infiltrate and hypopyon (settling of white blood cells at the base of the anterior chamber) developed in his left eye. Confocal microscopy showed findings concerning for Acanthamoeba infection and the contact lenses and case were sent for culture. Environmental organisms including Klebsiella varicola, Chryseobacterium gleum, and Pseudomonas fluorescens were recovered. In addition, cultures for Acanthamoeba sp., where sample is overlaid on a lawn of E. coli grown on a non-nutrient agar plate, were sent to a reference laboratory.
The patient was treated with Brolene, polyhexamide biguanide (PHMB), and chlorhexidine for Acanthamoeba as well as with antibacterial agents. Three months later his LASIK flap failed and was removed and sent for cultures and pathology which both grew Acanthamoeba sp.(Image 1). He continued treatment for another two months, but the corneal defect expanded. He underwent a therapeutic penetrating keratoplasty, and the explant cornea was sent for pathology. Sections showed acute and chronic inflammation of the corneal epithelium and stroma with rare cysts of Acanthamoeba with atypical morphology possibly representing treatment effect or nonviable organisms (Image 2). The patient continued treatment for another month afterward with resolution of symptoms.


Discussion
Acanthamoeba sp. are free-living amoebae found ubiquitously in the environment including in water, soil, dust, and air conditioning ducts.1 Over 20 species of Acanthamoeba have been identified, with eight known to cause human disease. A. castellani and A. polyphaga are the most common species identified from clinical infections.2 Acanthamoeba sp. are a primary reservoir of Legionella pneumophilia and can serve as vectors for other bacterial infections.3 These organisms may colonize the nasal passages of normal hosts.4 Acanthamoebal infections have varied clinical presentations depending on the route of transmission, organ(s) infected, and immune status of the host. These include amebic keratitis, granulomatous amebic encephalitis, and disseminated disease.3 Of these, Acanthamoeba keratitis (AK) is the most frequently encountered clinically.
AK can occur when the organisms are inoculated into corneal micro-abrasions, most often from contaminated hard contact lenses rinsed with tap water. AK represents 5% of all cases of contact-lens-associated keratitis, and 70-85% of AK cases are associated with contact lens use.1 Diagnosis of AK is heavily dependent on a high index of suspicion as AK presents with nonspecific ocular symptomology including blurred vision, photophobia, inflammation, and eye pain. A corneal ring infiltrate is characteristic, but only present in 50% of cases.1 Although historically culture is the gold standard for diagnosis, advanced technologies like confocal microscopy and PCR have greatly improved sensitivity and time to diagnosis.5 Cultures are usually grown on agar plates coated with gram negative bacilli such as E. coli.2 If Acanthamoeba are present, trails of bacterial clearing can usually be seen within days but may take up to several weeks.2 They have dormant cyst and active trophozoite forms. Microscopically they appear as round heterogeneous bodies with a distinct nucleus and surrounded by ruffled membrane and are 15-35 μm in length.3 PCR, given its analytical sensitivity, specificity and turn around time, is the more common method of diagnosis of AK and has replaced many instances of culture today.
AK has a poor prognosis and is potentially sight threatening. Factors contributing to disease severity include delayed diagnosis, pathogenic factors, and lack of effective medical management.1 Nearly 40% of patients fail initial therapy.1 Factors that contribute to Acanthamoeba pathogenicity include production of enzymes including elastases and proteases, adhesion molecules, and physiologic tolerance to different temperatures, osmolarities, and pH.6 The cyst stage confers resilience to many therapies which is compounded by poor tissue penetration of the antimicrobial agents often used in therapy.6 Repeated exposure to therapeutic antimicrobials can also lead to the development of resistance.6 In our patient’s case, treatment was successful following the LASIK flap removal, facilitating increased drug penetration and supported by pathologic findings of treatment effect in the explanted cornea.
References
- Somani SN, Ronquillo Y, Moshirfar M. Acanthamoeba Keratitis. 2021 Aug 11. In: StatPearls [Internet]. Treasure Island (FL): StatPearls Publishing; 2021 Jan–. PMID: 31751053.
- Maycock NJ, Jayaswal R. Update on Acanthamoeba Keratitis: Diagnosis, Treatment, and Outcomes. Cornea. 2016 May;35(5):713-20. doi: 10.1097/ICO.0000000000000804. PMID: 26989955.
- Marciano-Cabral F, Cabral G. Acanthamoeba sp. as agents of disease in humans. Clin Microbiol Rev. 2003 Apr;16(2):273-307. doi: 10.1128/CMR.16.2.273-307.2003. PMID: 12692099; PMCID: PMC153146.
- Clarke B, Sinha A, Parmar DN, Sykakis E. Advances in the diagnosis and treatment of Acanthamoeba keratitis. J Ophthalmol. 2012;2012:484892. doi: 10.1155/2012/484892. PMID: 23304449; PMCID: PMC3529450.
- Hoffman, J.J., Dart, J.K.G., De, S.K. et al. Comparison of culture, confocal microscopy and PCR in routine hospital use for microbial keratitis diagnosis. Eye (2021). https://doi.org/10.1038/s41433-021-01812-7
- Lorenzo-Morales J, Khan NA, Walochnik J. An update on Acanthamoeba keratitis: diagnosis, pathogenesis and treatment. Parasite. 2015;22:10. doi: 10.1051/parasite/2015010. PMID: 25687209; PMCID: PMC4330640.
-Tim Kirtek is a fourth year AP/CP resident at UT Southwestern Medical Center in Dallas, Texas.
-Dominick Cavuoti is a professor at UT Southwestern Medical Center who practices Medical Microbiology, Cytology and Infectious Disease Pathology.

-Andrew Clark, PhD, D(ABMM) is an Assistant Professor at UT Southwestern Medical Center in the Department of Pathology, and Associate Director of the Clements University Hospital microbiology laboratory. He completed a CPEP-accredited postdoctoral fellowship in Medical and Public Health Microbiology at National Institutes of Health, and is interested in antimicrobial susceptibility and anaerobe pathophysiology.

-Clare McCormick-Baw, MD, PhD is an Assistant Professor of Clinical Microbiology at UT Southwestern in Dallas, Texas. She has a passion for teaching about laboratory medicine in general and the best uses of the microbiology lab in particular.